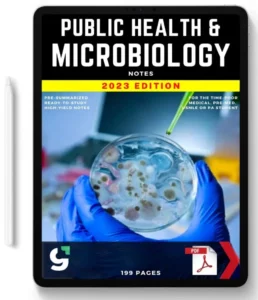

Need help? Call us:
number
number
Save TIME, Avoid BURNOUT, ACE Your Exams! Essential for Medical, MBBS, MD, MBChB, USMLE, PA, & Nursing Revision!
Crafted by Doctors! Used by over 97k Students!

You cannot copy content of this page